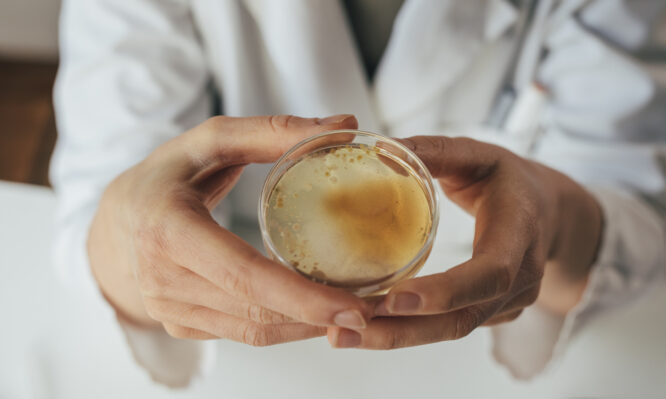
μύκητας
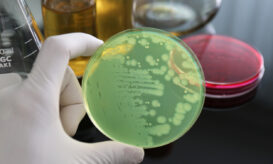
μύκητας
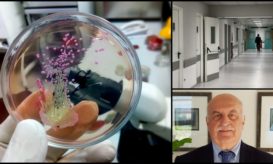

Candida auris: Τι προκαλεί ο ανθεκτικός μύκητας και γιατί ανησυχεί τους ειδικούς
Τι αναφέρει ο Εθνικός Οργανισμός Δημοσίας Υγείας (ΕΟΔΥ) σε νέο επιδημιολογικό δελτίο που εξέδωσε.
Τι αναφέρει ο Εθνικός Οργανισμός Δημοσίας Υγείας (ΕΟΔΥ) σε νέο επιδημιολογικό δελτίο που εξέδωσε.

Ενημέρωση για τον μύκητα Candida Auris από το Κέντρο Κλινικής Επιδημιολογίας και Έκβασης Νοσημάτων (CLEO).

Ο επικίνδυνος μύκητας Candidozyma auris (σ.σ. η σύγχρονη ονομασία του μύκητα Candida auris) εξακολουθεί να εξαπλώνεται ραγδαία στα νοσοκομεία...
Η Ελλάδα είναι μία από τις πέντε ευρωπαϊκές χώρες με τα περισσότερα κρούσματα στην ΕΕ.

Τι αναφέρει η καθηγήτρια Ελένη Γιαμαρέλλου. Τι προκαλεί στους ασθενείς που μολύνει και πως αντιμετωπίζεται.

Ο πολυανθεκτικός μύκητας Candida Auris έχει προκαλέσει 122 θανάτους σε ελληνικά νοσοκομεία μέσα σε 3 χρόνια.

Σοβαρή ανησυχία έχει προκαλέσει στους επιστήμονες, η αυξανόμενη παρουσία του παθογόνου πολυανθεκτικού μύκητα Candida Auris στα ελληνικά νοσοκομεία.

Μεγάλη διασπορά και θανάτους σε ΜΕΘ έχει προκαλέσει και στην Ελλάδα, ο μύκητας Candida Auris.

Συναγερμός έχει σημάνει στα ελληνικά νοσοκομεία, με αφορμή την έξαρση του πολυανθεκτικού μύκητα Candida Auris στις ΗΠΑ.

Αυξημένη ανησυχία υπάρχει στη διεθνή επιστημονική κοινότητα για την καλπάζουσα αύξηση της επιδημίας του πολυανθεκτικού μήκυτα Candida Auris, που...

Περίπου το 30-60% των ασθενών που μολύνθηκαν με C. auris έχουν πεθάνει.
Σε απομόνωση βρίσκεται ο 64χρονος ασθενής στο Πανεπιστημιακό Νοσοκομείο Ηρακλείου (ΠΑΓΝΗ), στον οποίο εντοπίστηκε ο πολυανθεκτικός μύκητας Candida auris....

Συναγερμός στο Πανεπιστημιακό Νοσοκομείο Ηρακλείου καθώς εντοπίστηκε κρούσμα candida auris σε ασθενή που νοσηλεύεται σε κλινική του ΠΑΓΝΗ.

Στο φως της δημοσιότητας βρέθηκε πρόσφατα ο πολυανθεκτικός -φονικός για τον άνθρωπο- μύκητας Candida auris, ο οποίος ενδημεί στα...

Τη διερεύνηση που πραγματοποιεί ο ΕΟΔΥ για τον έγκαιρο εντοπισμό των ενδονοσοκομειακών λοιμώξεων στα νοσοκομεία όλης της χώρας, αναλύει...